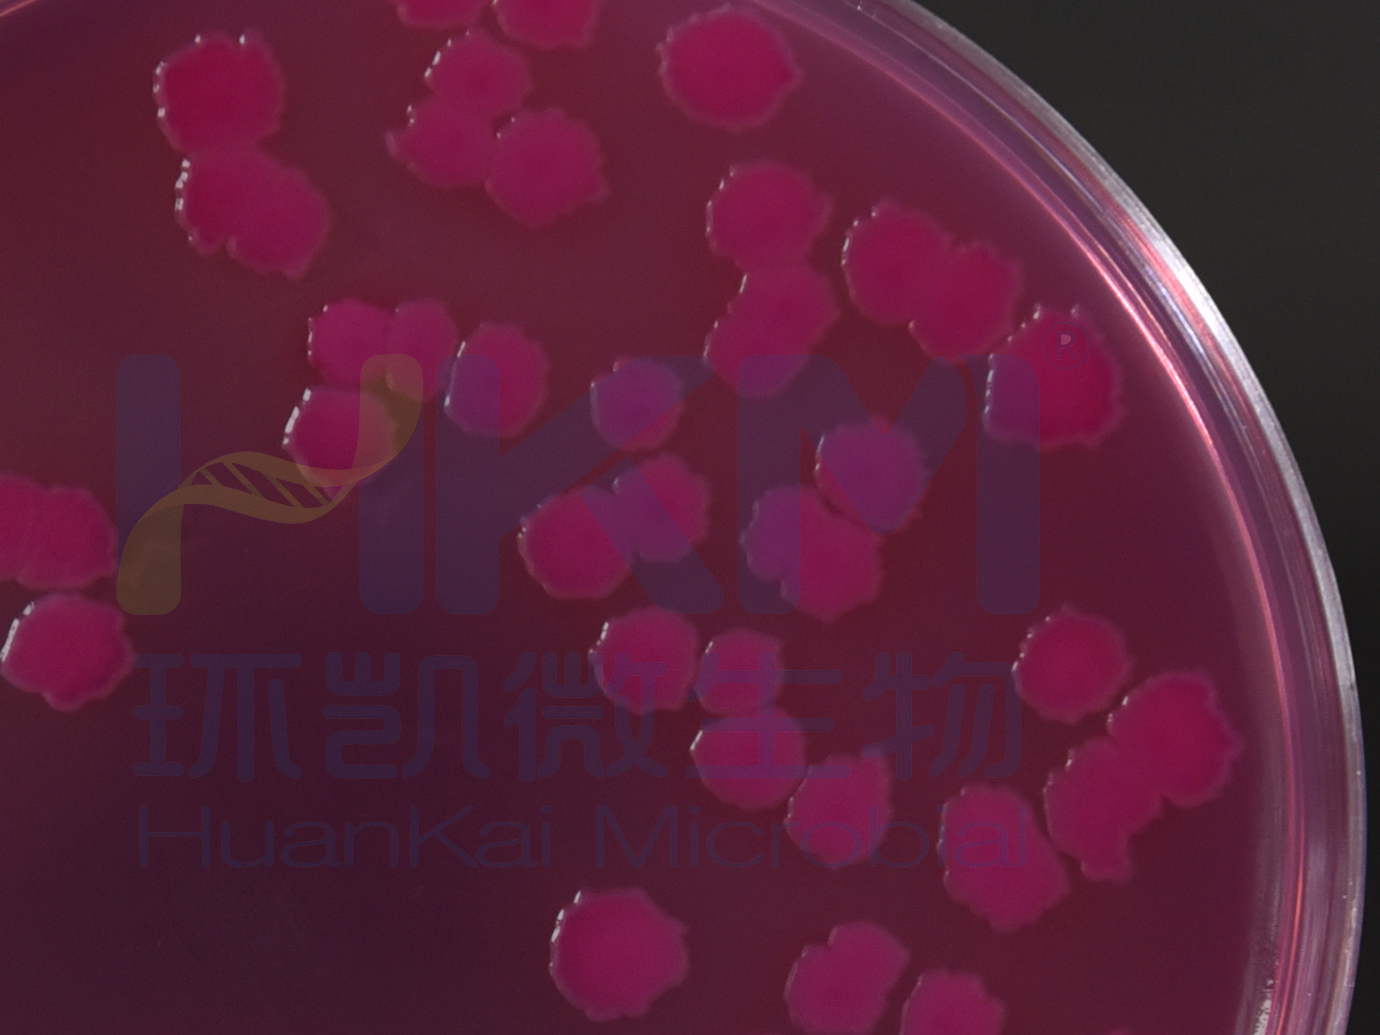
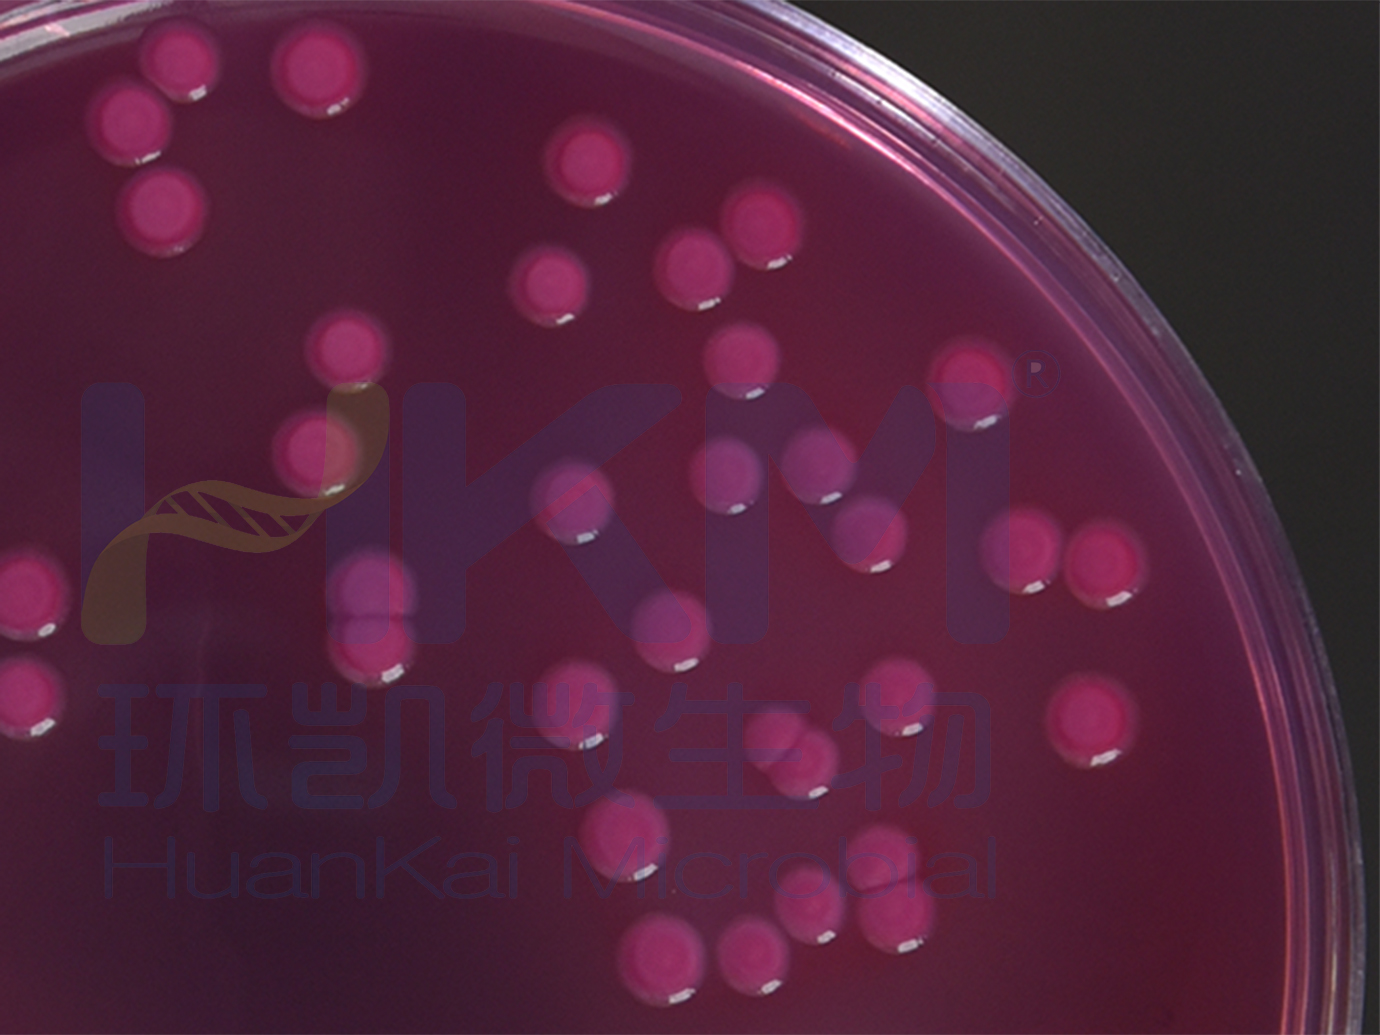
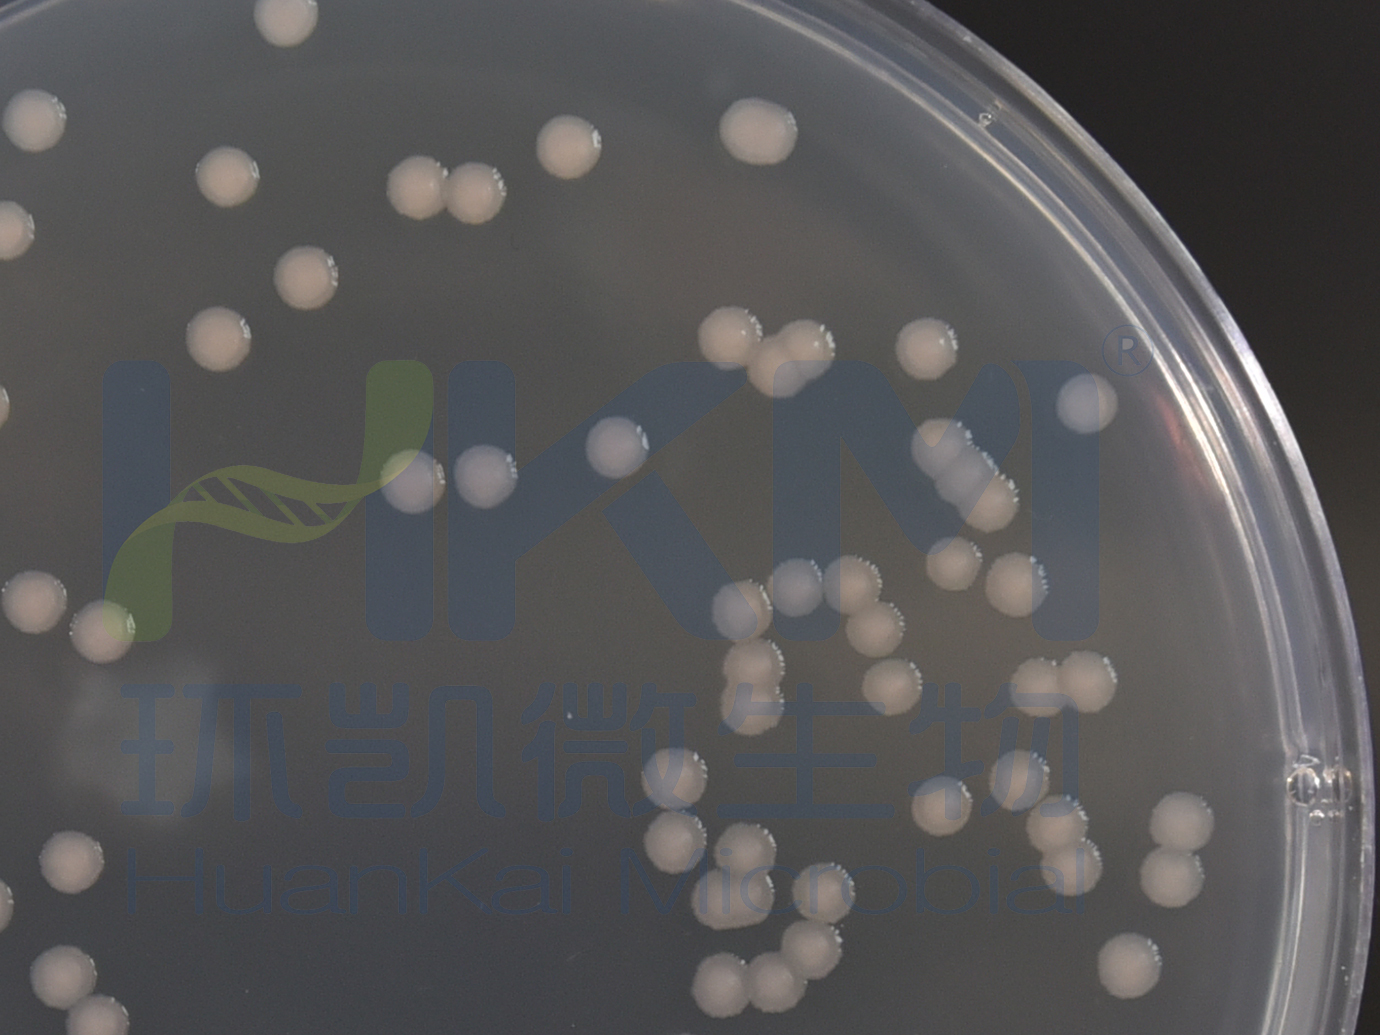
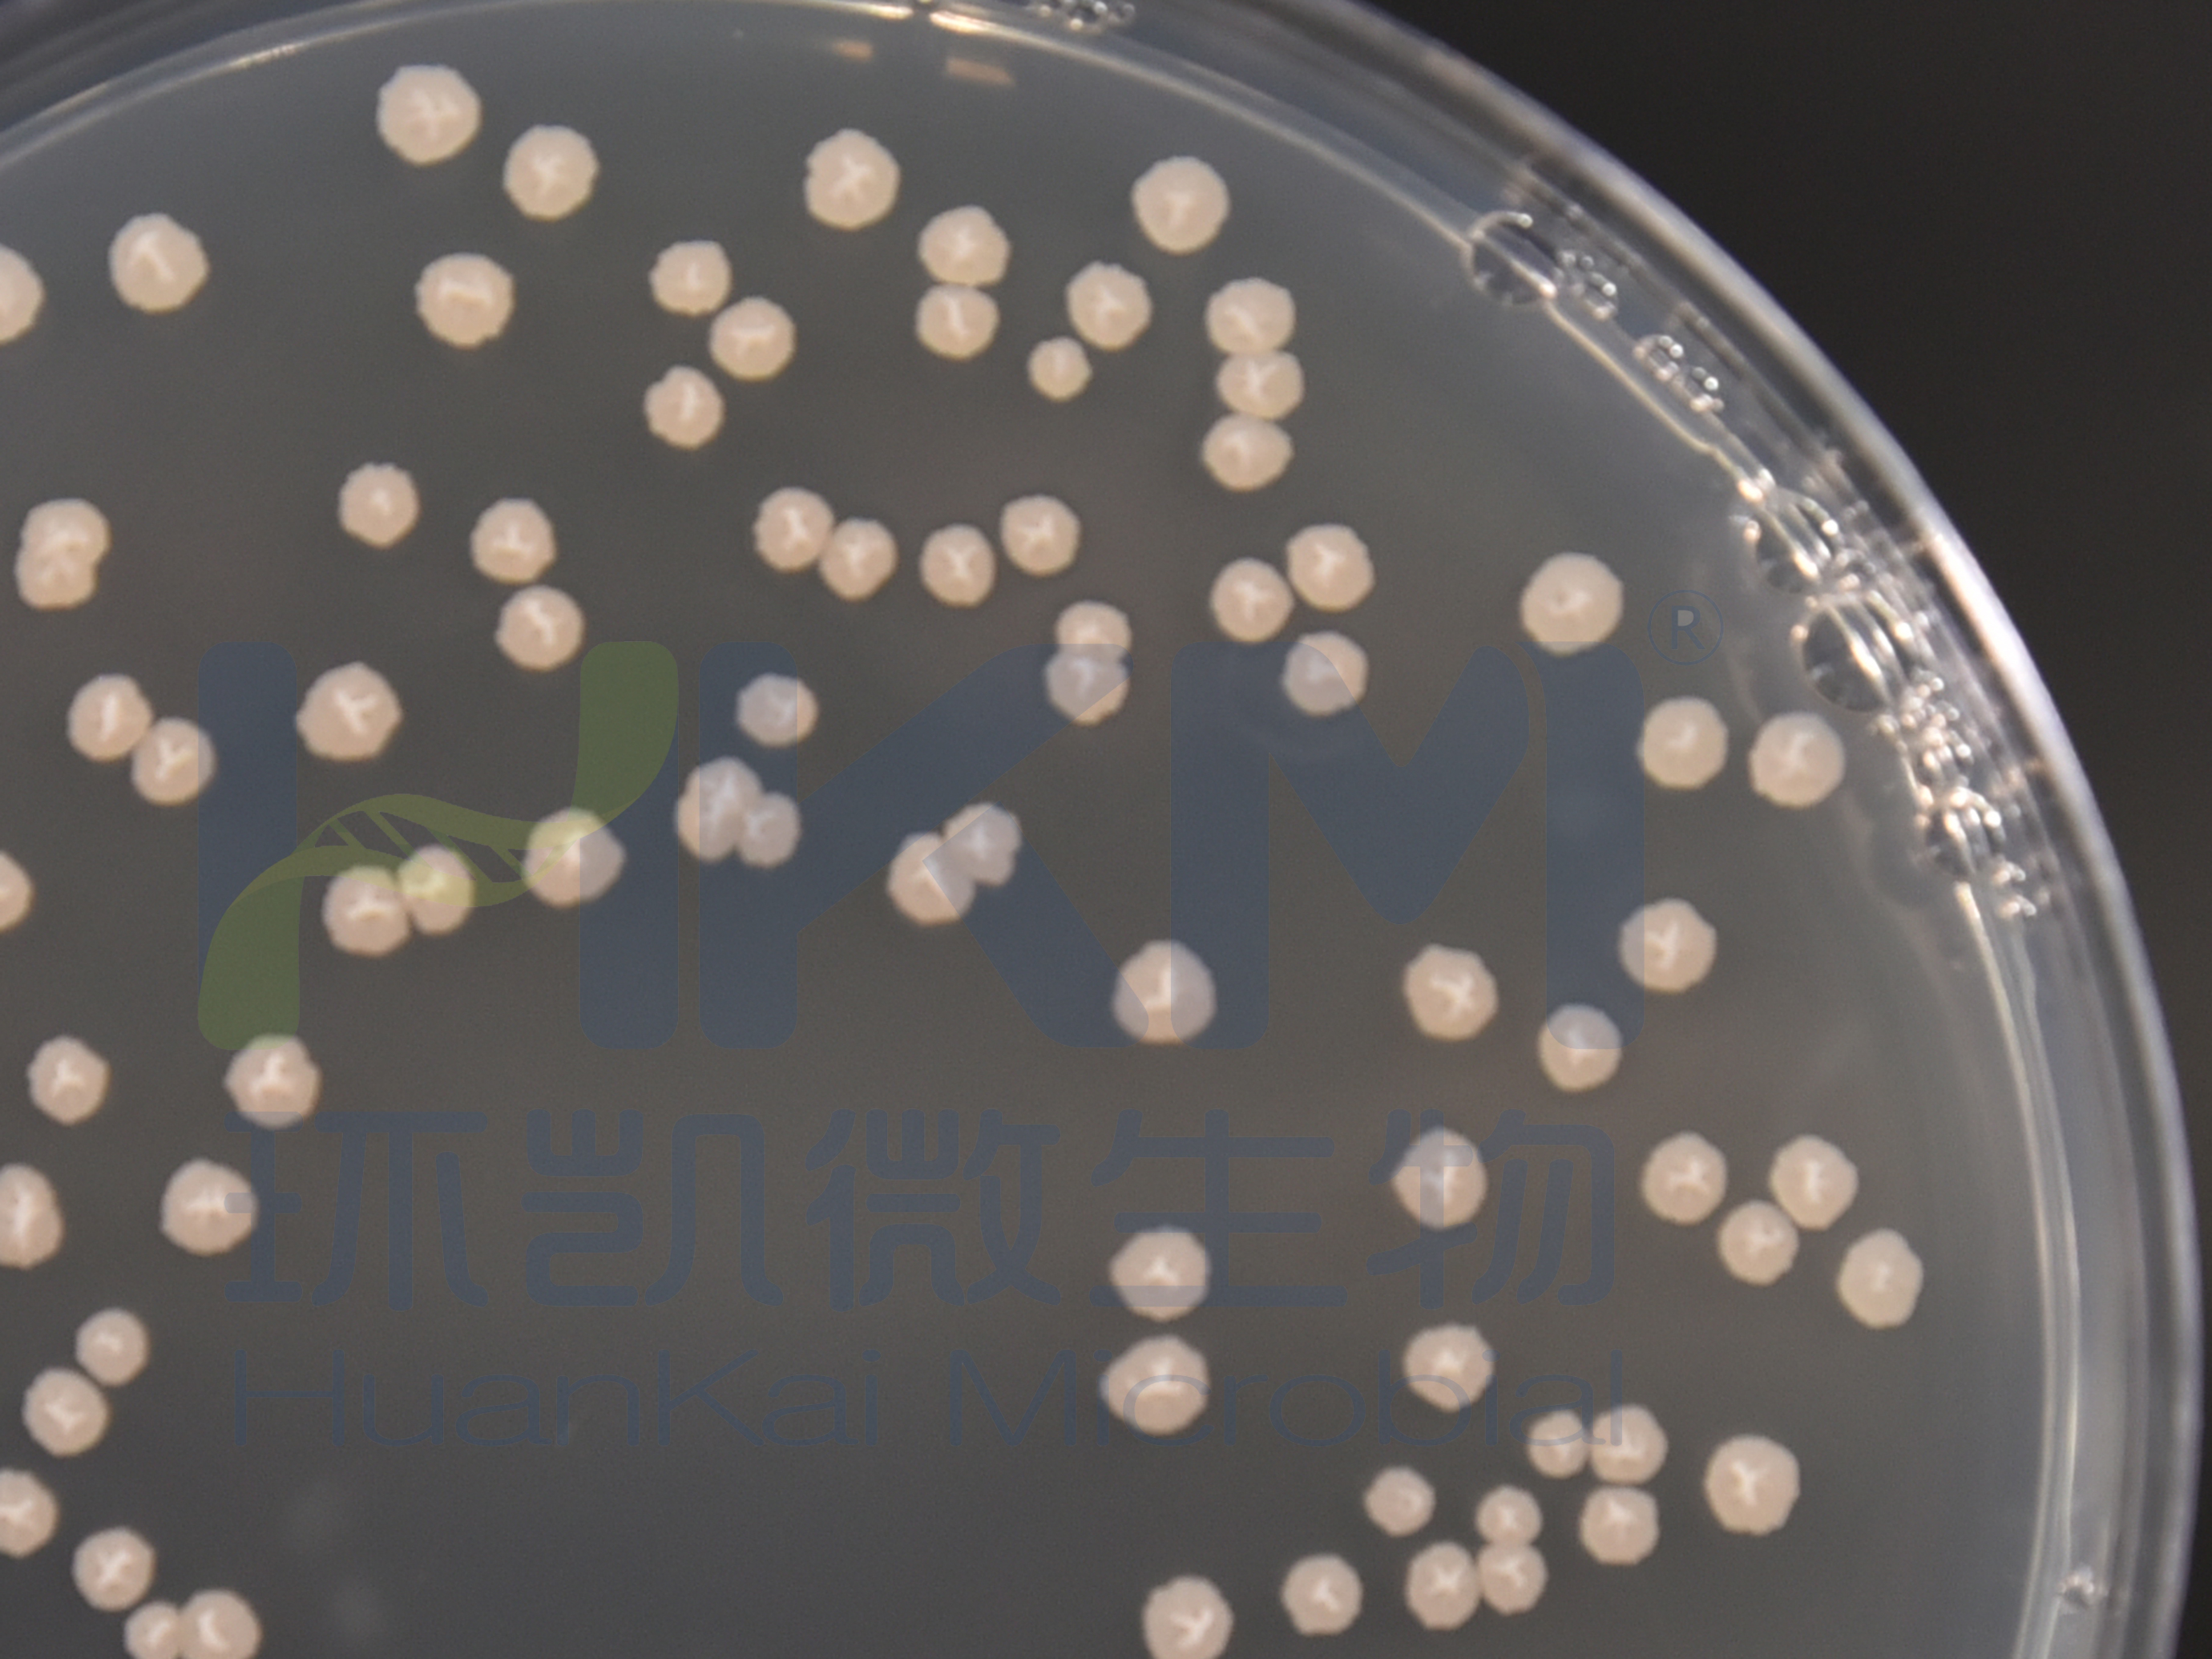
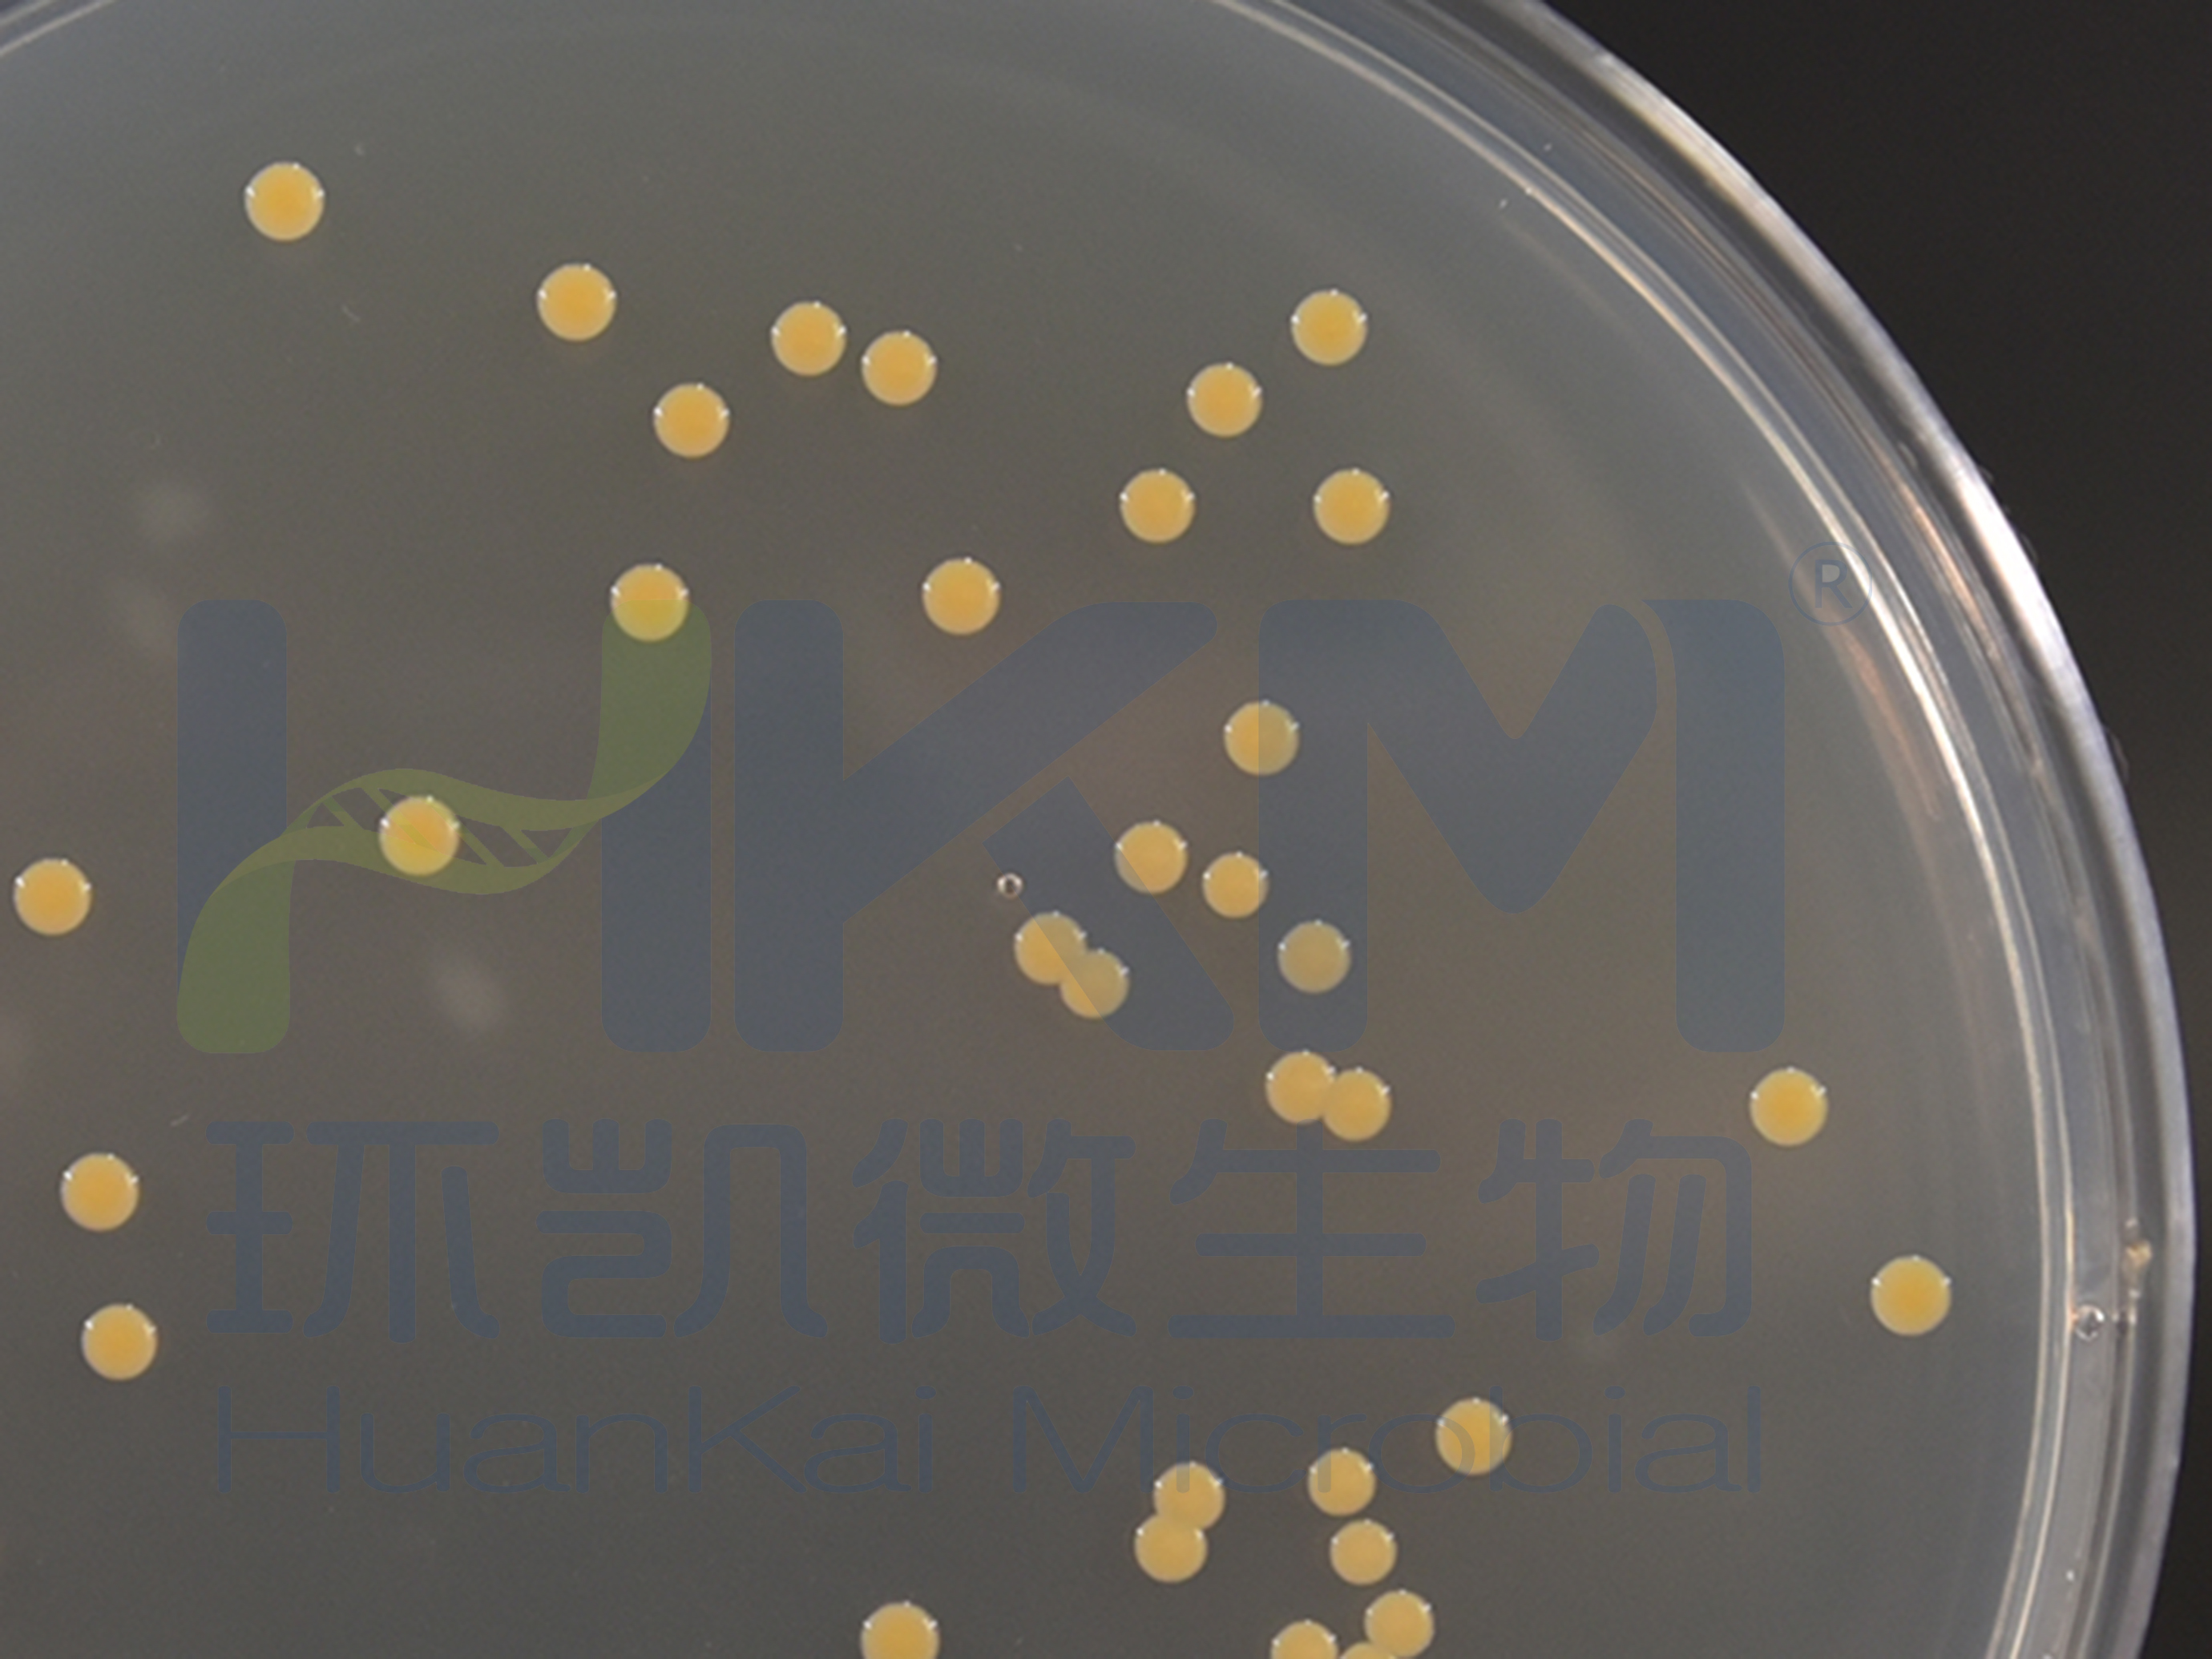
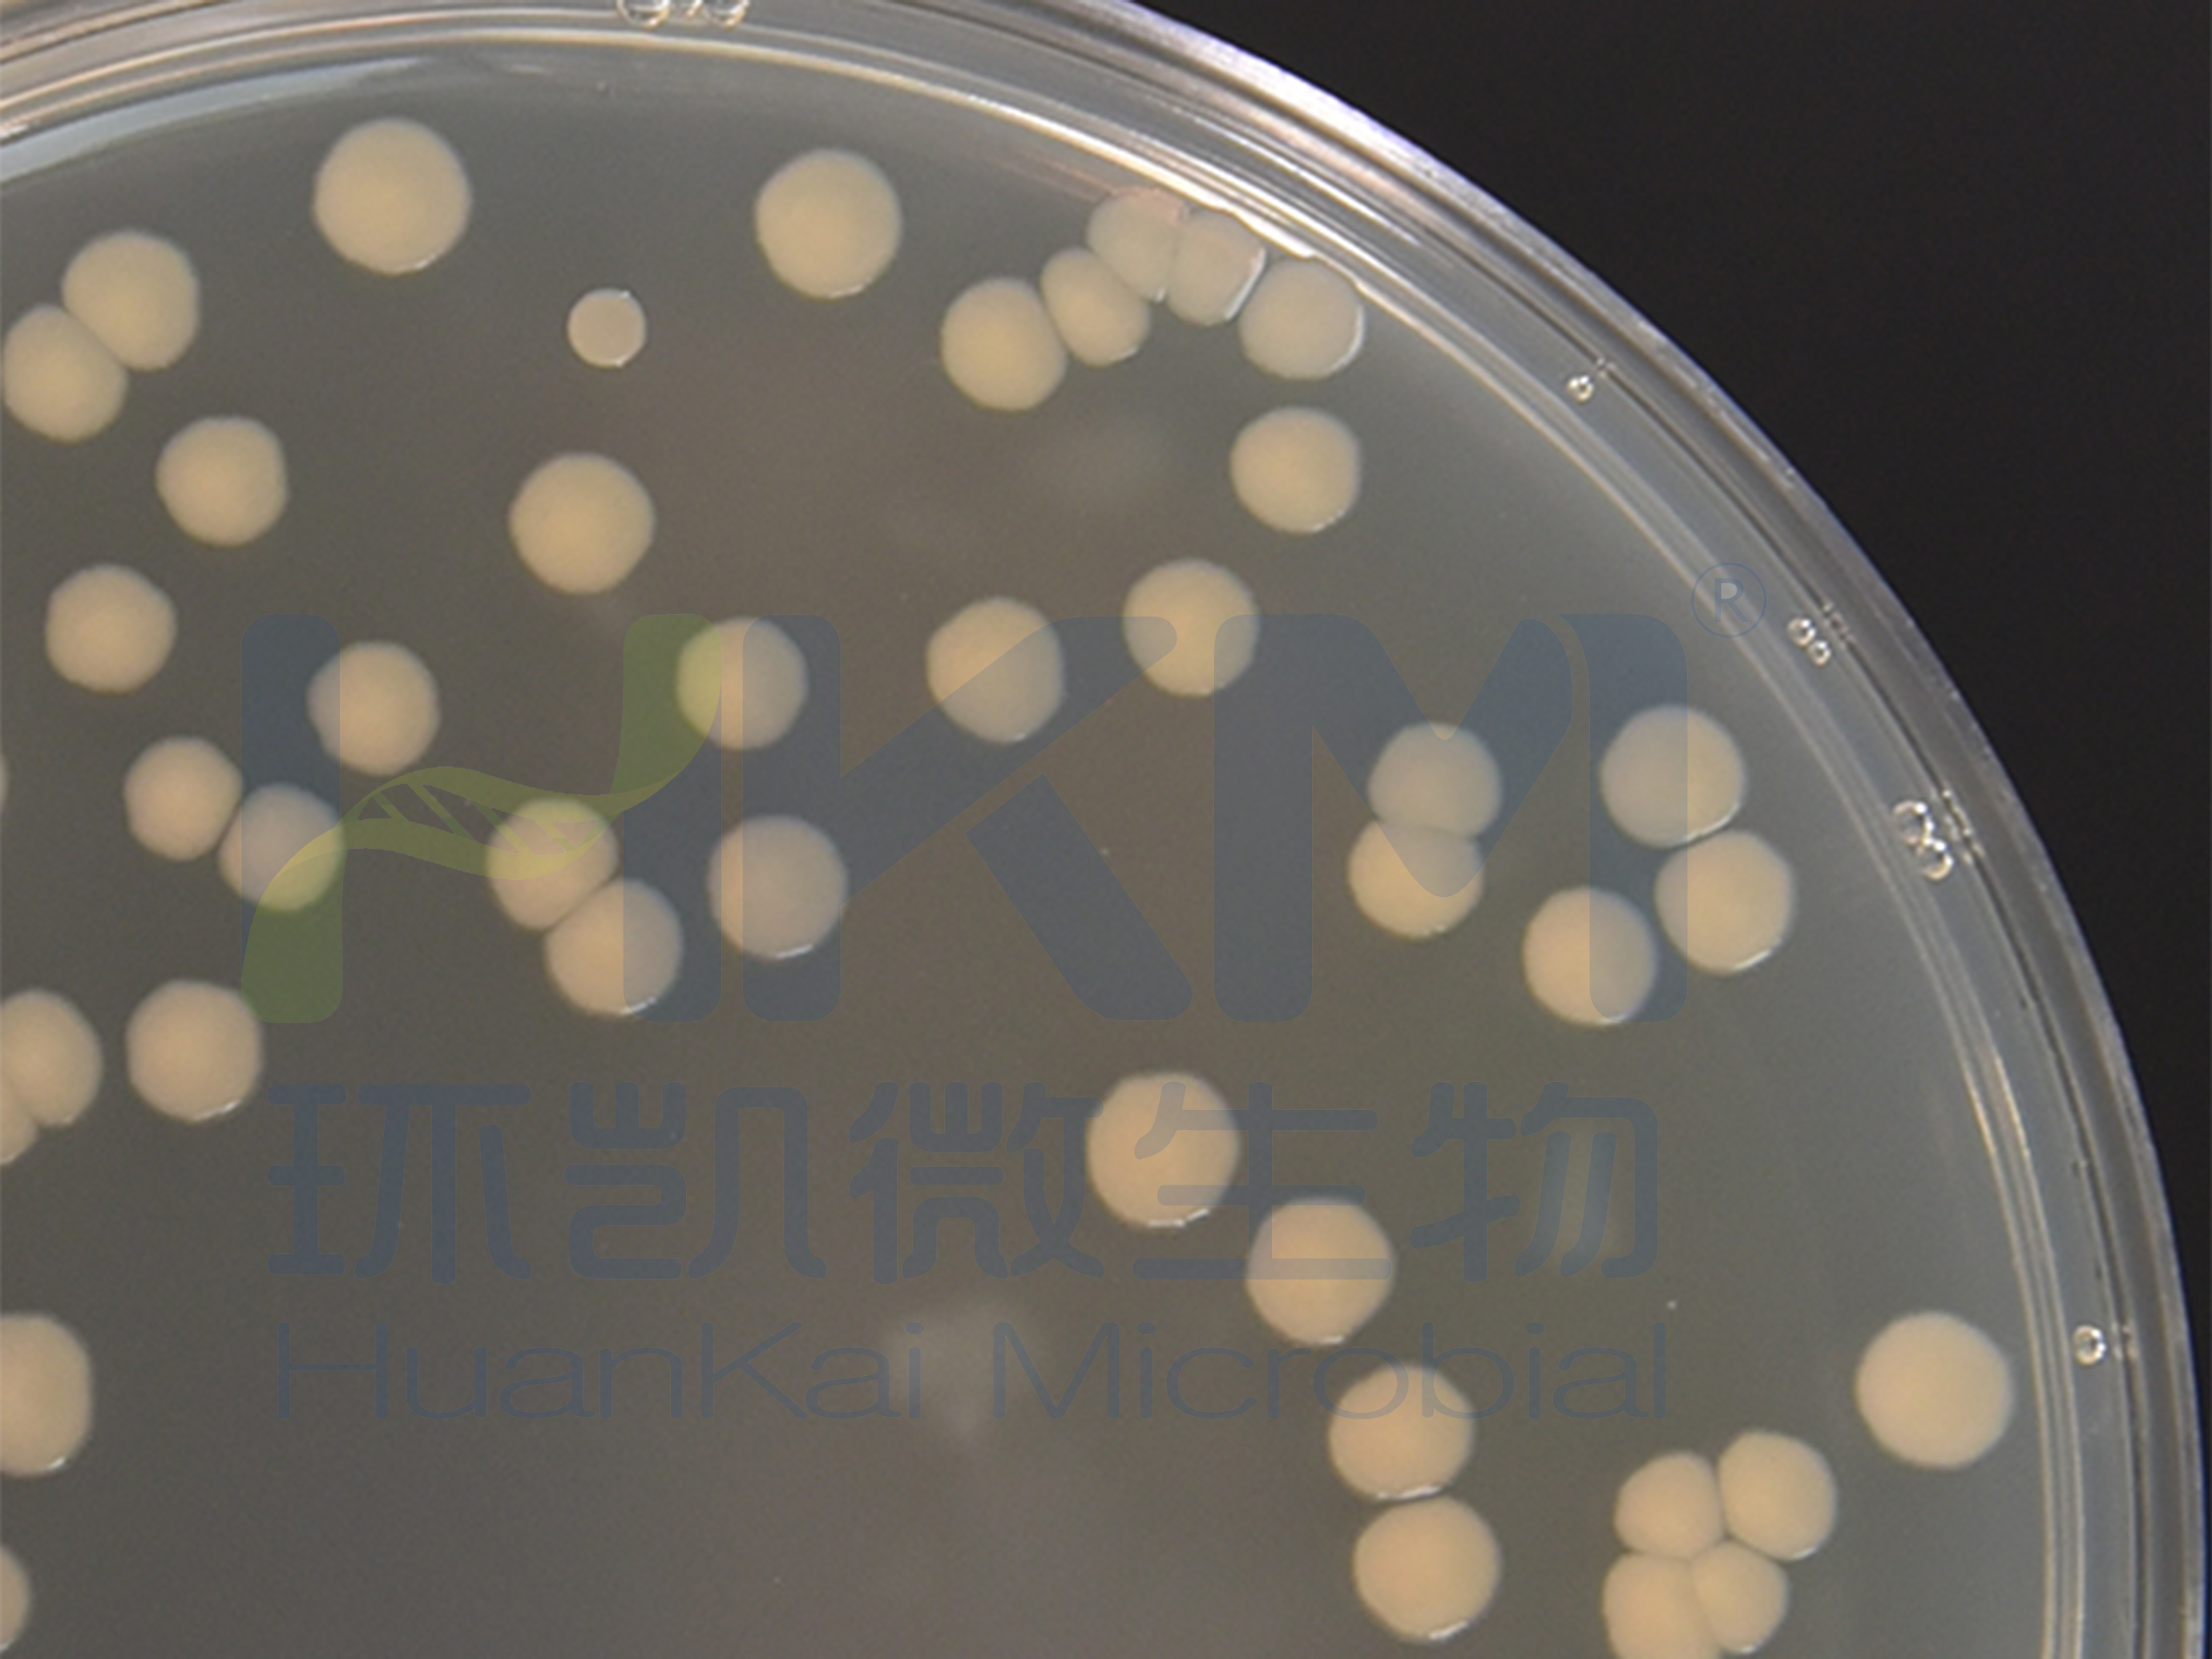
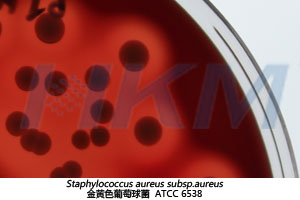

022221 结晶紫中性红胆盐琼脂VRBA-弗氏柠檬酸菌ATCC43864
022221 结晶紫中性红胆盐琼脂VRBA-大肠埃希氏菌ATCC25922
022020 营养琼脂NA-铜绿假单胞菌ATCC9027
022020 营养琼脂NA-枯草芽孢杆菌ATCC6633
022020 营养琼脂NA-金黄色葡萄球菌ATCC6538
022020 营养琼脂NA-大肠杆菌ATCC25922

021011 玫瑰红纳琼脂培养基 - 黑曲霉CMCC98003

金黄色葡萄球菌 ATCC6538

金黄色葡萄球菌 ATCC6538
金黄色葡萄球菌 ATCC6538

白色念珠菌 ATCC10231

黑曲霉菌 ATCC16404






